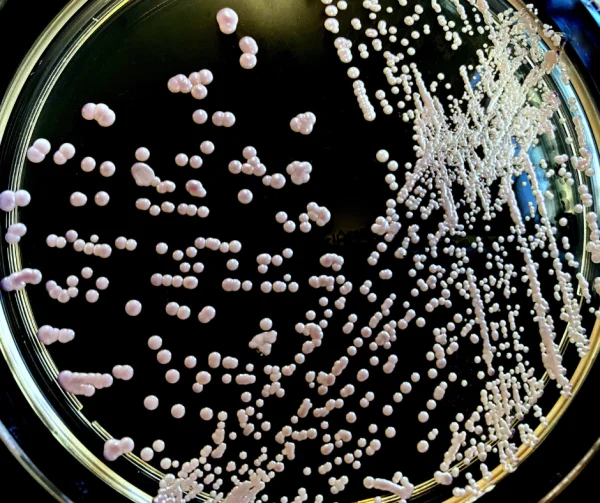
BẠN CÓ BIẾT SACHAROMYCES CEREVISIAE LÀ GÌ? NẤM MEN CÓ LỢI HAY CÓ HẠI TRONG CHĂN NUÔI ?

Chiến binh thầm lặng tiêu diệt vi khuẩn có hại - Lactobacillus spp
![]() Là nhóm vi khuẩn hình que không sinh nha bào. Có hơn 50 loài được tìm thấy nhiều trong hệ tiêu hóa, hệ bài tiết, hệ sinh dục. Với các loài thường gặp như: Lactobacillus acidophilus, Lactobacillus paracasei, Lactobacillus plantarum, Lactobacillus blugaricus, Lactobacillus rhamnosus .....
Là nhóm vi khuẩn hình que không sinh nha bào. Có hơn 50 loài được tìm thấy nhiều trong hệ tiêu hóa, hệ bài tiết, hệ sinh dục. Với các loài thường gặp như: Lactobacillus acidophilus, Lactobacillus paracasei, Lactobacillus plantarum, Lactobacillus blugaricus, Lactobacillus rhamnosus .....![]() Được ứng dụng rộng rãi trong nhiều lĩnh vực khác nhau: Thực phẩm, dược phẩm, nông nghiệp, công nghiệp, môi trường…
Được ứng dụng rộng rãi trong nhiều lĩnh vực khác nhau: Thực phẩm, dược phẩm, nông nghiệp, công nghiệp, môi trường…![]() Sản sinh acid lactic và một số chất kháng khuẩn giúp hạ pH đường ruột, ức chế sinh trưởng hoặc ngăn chặn vi khuẩn gây bệnh bám vào màng nhầy thành ruột
Sản sinh acid lactic và một số chất kháng khuẩn giúp hạ pH đường ruột, ức chế sinh trưởng hoặc ngăn chặn vi khuẩn gây bệnh bám vào màng nhầy thành ruột![]() Tăng sinh nhanh chóng trong chính môi trường giàu acid mà chúng tạo ra, từ đó tạo nên rào cản cho việc sinh sản của các vi sinh vật gây hại.
Tăng sinh nhanh chóng trong chính môi trường giàu acid mà chúng tạo ra, từ đó tạo nên rào cản cho việc sinh sản của các vi sinh vật gây hại.![]() Có nhiều nghiên cứu chứng minh vai trò của Lactobacillus trong việc kích hoạt hệ thống cytokin, tăng cường miễn dịch cho vật chủ.Bổ sung một số vitamin quan trọng cho vật chủ trong quá trình tăng sinh như: folic acid, riboflavin(B2), cobalamin(B12)…
Có nhiều nghiên cứu chứng minh vai trò của Lactobacillus trong việc kích hoạt hệ thống cytokin, tăng cường miễn dịch cho vật chủ.Bổ sung một số vitamin quan trọng cho vật chủ trong quá trình tăng sinh như: folic acid, riboflavin(B2), cobalamin(B12)…![]() Acid mật trong quá trình chuyển hóa có sự tác động của lợi khuẩn lactobacillus sẽ được thúc đẩy thêm, hỗ trợ việc hấp thu chất béo cho vật chủ, đồng thời cải thiện đáng kể khả năng hấp thụ các dưỡng chất
Acid mật trong quá trình chuyển hóa có sự tác động của lợi khuẩn lactobacillus sẽ được thúc đẩy thêm, hỗ trợ việc hấp thu chất béo cho vật chủ, đồng thời cải thiện đáng kể khả năng hấp thụ các dưỡng chất![]() Khi mà công nghệ sinh học càng phát triển thì Lactobacillus cũng ngày càng được khám phá và ứng dụng nhiều hơn
Khi mà công nghệ sinh học càng phát triển thì Lactobacillus cũng ngày càng được khám phá và ứng dụng nhiều hơn